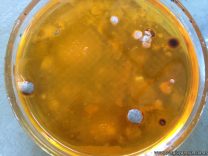

Los alumnos de 6to año, orientación Ciencias Naturales, en el espacio curricular Salud realizaron cultivo de microorganismos y luego de una semana efectuaron la observación macroscópica de las colonias y la microscópica en fresco.
Los alumnos de 6to año, orientación Ciencias Naturales, en el espacio curricular Salud realizaron cultivo de microorganismos y luego de una semana efectuaron la observación macroscópica de las colonias y la microscópica en fresco.
Noticia anterior/siguiente:

Seguí al colegio